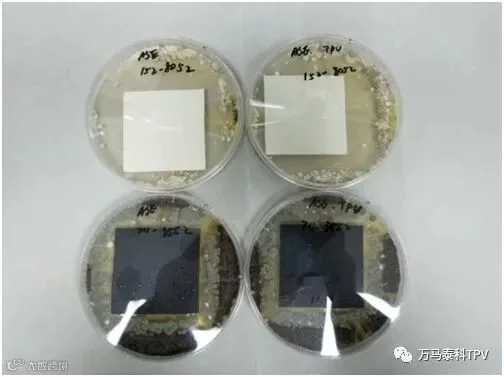

疫情之后,健康第一
目前,人们的安全健康意识得到空前提升,产品是否具备抗菌性?成为消费者关注的焦点。以前大家对抗菌消毒的意识差不多都停留在酒精、洗手液这些产品上面,但是现在很多人在咨询是否有抗菌类衣物、家电、厨房用品、抗菌地板等等众多日常生活用具。
据大数据统计,自2月以来,具备抗菌、过滤病毒功能的空气净化器销售火爆、多款抗菌类家电销售增长到200%,由此可看出是否具备抗菌功能已成为消费者购买产品的决定性因素之一了。
什么是抗菌弹性体材料
抗菌弹性体,是指在传统弹性体材料中添加具有抗菌作用的组份,使材料本身就具备抑制灭杀微生物的功能。
万马泰科新材料有限公司,结合市场需求,成功开发了抗菌型热塑性弹性体材料,不仅加工方便、性能优良,其对大肠杆菌和金黄色葡萄球菌灭杀率达到99%以上,符合国家一级标准。
抗菌弹性体材料的应用
1、车企
疫情之后,除了低气味、低VOCs等环保问题,抗菌抗毒逐渐成为消费者的关注重点。国内多家车企迅速反应,投入巨资研发抗菌抗病毒的“健康汽车”,进一步细化升级车内环保、健康的概念。如何实现内饰的健康环保成为众多研发人员的重要课题。
汽车内饰处在相对封闭的环境中,是细菌病毒滋生的“温床”,据法国健康杂志调查,车内每平方厘米就有800余种细菌,是厕所的十倍。
上汽、北汽、广汽、吉利等多家主机厂率先宣布为保证驾乘者的健康与安全,将通过内饰材料的和空调系统的抗菌级改造、开发智能健康系统来提高汽车座舱的健康性。
抗菌型热塑性弹性体材料应用在汽车内饰上,不仅具有低VOC、低气味特性、加工成型方便等特性,其优良的抗菌性,更能保证驾乘者的健康与安全。
2、家电
其实家电行业很早就推出过很多抗菌材料的产品,比如空调、洗衣机等,因为家电用品上有很多高频接触的部件。
通过这次疫情,抗菌的理念变得更加重要。消费者对此的重视程度是极大的,厂商关于抗菌的设计及研发力度也在不断提升,例如格力、美的、海尔纷纷推出抗菌级别的空调、洗衣机及冰箱等产品。
而抗菌级热塑性弹性体材料应用在家电密封上,不仅能解决其高低温密封性问题,更能抑制和灭杀细菌在该部位的滋生生长,从而保护家人的健康。
3、卫浴及涉水类消费产品
欧美早在20多年前,就开始在涉水及卫浴产品上的抗菌要求,因生活习惯的区别,其对涉水产品上的抗菌和健康要求更高,尤其是在直饮水及净水机产品上都有相关抗菌要求。
疫情之后国内的净水机、卫浴产品纷纷推出了抗菌概念产品,消费者在选择这块也更为注重健康安全性更高产品。
万马抗菌弹性体材料,所含有的银离子抗菌成分,不仅能够有效的灭杀潮湿环境中滋生的有害细菌,还兼具除臭除味的效果。
扫码关注我们
Tel:0571-63870153
178 5865 7207(孔经理)
Add:杭州青山湖街道景观大道81号

